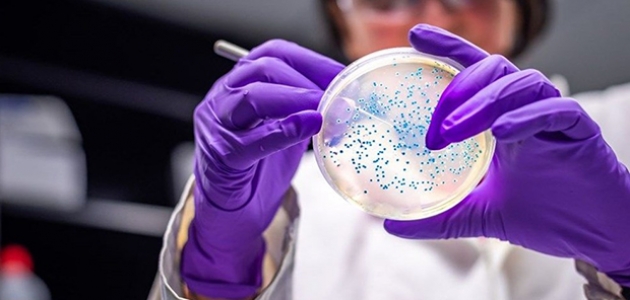

İlk olarak İngiltere’de Eylül ayında tespit edilen, Aralık ayına kadar da tanımlanamayan corona virüsün yeni mutasyonu birçok ülkeye sıçramaya başladı. Geçtiğimiz gün Türkiye'de de 15 kişide tespit edilen ve yüzde 70’e kadar daha fazla bulaşıcı olduğu belirtilen corona virüs mutasyonu bugüne kadar 33 ülkede tespit edildi. İşte B.1.1.7 olarak adlandırılan corona virüsün yeni varyantının görüldüğü ülkeler...
Reklam alanı
İNGİLTERE - İRLANDA
İngiltere, Eylül ayında corona virüsün yeni varyantını bildiren ilk ülke oldu.
Aralık ayında Sağlık Bakanı Matt Hancock, yeni varyantın "kontrolden çıktığını" söyledi. Hancock, hükümeti daha sıkı karantina tedbirleri almaya ve birçok ülkeye seyahat kısıtlaması getirmeye çağırdı.
İrlanda Başbakanı Micheal Martin Çarşamba günü televizyonda yaptığı bir konuşmada, ülkede corona virüsün yeni varyantının tahmin edilebilecek en kötü seviyede yayıldığını açıklarken herhangi bir rakam vermekten kaçındı.
HOLLANDA - BELÇİKA
Hollanda, İngiltere'den sonra corona virüsün yeni varyantının bulduğunu açıklayan ilk Avrupa ülkelerinden biri oldu.
22 Aralık'ta Hollanda Sağlık Bakanı Hugo de Jonge, yeni varyantın Amsterdam bölgesinde iki vakada bulunduğunu söyledi.
Afp’ye göre, Belçika’da Aralık başında en az dört kişide corona virüsün yeni varyantı tespit edildi.
Belçika Sağlık Bakanlığı sözcüsü Yves Van Laethem, "Tespit edilen sayı çok değil ama daha fazla olması da imkansız değil" şeklinde konuştu.
TÜRKİYE
Türkiye Sağlık Bakanı Fahrettin Koca, geçtiğimiz gün 15 kişide corona virüsün yeni varyantının tespit edildiğini açıkladı. Koca, kişilerin karantina altına alındıklarını belirtti.
Koca, İngiltere'den son dönemde yurda giriş yapan 15 kişide yeni mutasyon ile uyumlu virüs tespit edilmesi üzerine, bu ülkeden yurda girişlerin geçici olarak tamamen durdurulduğunu duyurdu.
FRANSA
Fransa corona virüs mutasyonunun ilk vakasını Noel Günü'nde tespit etti. Yetkililer, kişinin Londra'dan dönen bir Fransız vatandaşı olduğunu söyledi.
İSVEÇ - DANİMARKA
İsveç sağlık kurumunun 26 Aralık'ta yaptığı açıklamada, İngiltere'den ülkeye gelen bir yolcuda corona virüsün yeni varyantı tespit edildi. Yetkililer enfekte olan kişinin izole edildiğini ve daha sonra herhangi bir vakanın tespit edilmediğini açıkladı.
Dünya Sağlık Örgütü, Noel haftasında Danimarka'da dokuz kişide corona virüsün yeni varyantının tespit edildiğini açıkladı.
İSPANYA - PORTEKİZ
İspanya’da sağlık yetkilileri 26 Aralık'ta ülkede corona virüsün yeni varyantının görüldüğü dört kişi olduğunu açıkladı.
Bu kişilerin İngiltere'den gelen kişiler olduğunu belirten yetkililerden Madrid bölge hükümetinin sağlık şef yardımcısı Antonio Zapatero, "Hastalar ciddi şekilde hasta değil. Bu türün daha bulaşıcı olduğunu biliyoruz, ancak daha ciddi hastalığa neden olmuyor" dedi.
Portekiz, 21 Aralık itibarıyla Portekiz'in özerk bölgesi Madeira adasında en az 18 corona virüs varyantının tespit edildiğini açıkladı.
İSVİÇRE
kayak pistlerini Noel ve yeni yıl tatilleri döneminde açık tutan tek Avrupa ülkesi olan İsviçre’de Federal Halk Sağlığı Dairesi (FOPH) 26 Aralık'ta yaptığı açıklamada, corona virüsün yeni varyantının üç kişide görüldüğünü açıkladı.
Hastalardan ikisinin Birleşik Krallık'ta yaşayan ancak ülkeyi sık sık ziyaret eden kişiler olduğu belirtilirken Federal Halk Sağlığı Dairesi sözcüsü "Tüm yakın temaslılar belirlendi ve karantinaya alındı" dedi.
ALMANYA
Alman sağlık yetkilileri 29 Aralık'ta, corona virüsün yeni varyantının Kasım ayından bu yana ülkede olduğunu söyledi. Yetkililer, varyantın sağlık sorunları olan ve hayatını kaybeden yaşlı bir hastada tespit edildiğini açıkladılar.
Ülke ayrıca, Londra’dan Frankfurt'a seyahat eden ve 20 Aralık'ta corona virüs testi pozitif çıkan bir kişide daha corona virüsün yeni varyantı tespit edildi.
İTALYA - MALTA
İtalyan yetkililer, İngiltere'den Roma'ya uçan bir çiftte corona virüsün yeni varyantını tespit ettiklerini söylediler.
Akdeniz’de ada ülkesi olan Malta, geçtiğimiz Çarşamba günü üç corona virüs mutasyonu vakası bildirdi.
KANADA
26 Aralık'ta Kanada'nın Ontario eyaletindeki bir çiftte, corona virüsün yeni varyantı tespit edildi.Yetkililer çiftin yüksek riskli temasta olmadıklarını ve kendi kendilerini karantinaya aldıklarını açıkladı.
JAPONYA
Japonya, Noel günü beş kişide corona virüsün yeni varyantının görüldüğünü açıkladı.
28 Aralık itibarıyla yeni seyahat kurallarını açıklayan ülkeye gidişlerden 72 saat önce negatif test ve vardıklarında iki hafta karantina kuralı getirildi.
TAYVAN - SİNGAPUR
Tayvan Sağlık Bakanı Chen Shih-chung Çarşamba günü yaptığı açıklamada, İngiltere'den seyahat eden 10 yaşındaki bir erkek çocuk da dahil olmak üzere üç yolcuda corona virüsün yeni varyantının tespit edildiğini açıkladı.
Singapur Sağlık Bakanlığı, 24 Aralık günü ülkelerinde corona virüsün yeni varyantının tespit edildiğini açıkladı.
AVUSTRALYA
Ülkede, New South Wales eyaletin baş sağlık görevlisi Kerry Chant, Birleşik Krallık'tan gelen bir uçuşun ardından Avustralya'nın New South Wales şehrinde corona virüsün yeni varyantını taşıyan iki vakasının tespit edildiğini söyledi.
BİRLEŞİK ARAP EMİRLİKLERİ
Birleşik Arap Emirlikleri'nden bir hükümet yetkilisi yaptığı açıklamada, ülkede corona virüsün yeni varyantının "sınırlı sayıda" bulunduğunu söyledi. Yetkili, vakaların yurt dışından geldiğini belirtirken hangi ülkeden ya da kaç kişide görüldüğü hakkında açıklama yapmadı.
HİNDİSTAN
Hindistan, 29 Aralık Salı günü sekiz kişide corona virüsün yeni varyantının tespit edildiğini açıkladı. Tespit edilen kişilerin hepsinin İngiltere’den geldiği belirtilirken kişilerin karantinaya alındıkları ifade edildi.
GÜNEY KORE
Kore Hastalık Kontrol ve Önleme Dairesi 28 Aralık'ta Güney Kore'de üç kişide corona virüsün yeni varyantının görüldüğünü duyurdu. 22 Aralık'ta Londra'dan gelen bir ailenin varyanta sahip olduğu ve o zamandan beri karantinada oldukları belirtildi.
ÇİN
Geçtiğimiz Çarşamba günü, Çin Hastalık Kontrol ve Önleme Merkezi ülkede corona virüsün yeni varyantının görüldüğünü duyurdu.
İngiltere'den Çin'e dönen 23 yaşındaki bir öğrencide tespit edilen mutasyonlu corona virüsün 14 Aralık'ta Şangay'da yapılan test sonrası ortaya çıktığı açıklandı.
FİNLANDİYA - NORVEÇ
Finlandiya Sağlık yetkilileri 28 Aralık Pazartesi günü yaptıkları açıklamada, İngiltere'den kısa süre önce dönen bir Finlandiya vatandaşında corona virüsün yeni varyantının görüldüğünü duyurdu. Norveç Halk Sağlığı Enstitüsü Pazar günü yaptığı açıklamada, Birleşik Krallık'tan gelen yolcuların ikisinde corona virüs mutasyonunun tespit edildiğini açıkladı.
PAKİSTAN
Pakistan, 29 Aralık'ta İngiltere'den gelen bir uçaktaki altı yolcuda corona virüsün yeni varyantının görüldüğünü duyurdu.Pakistan yönetimi, 4 Ocak’a kadar İngiltere’ye seyahat yasağı uygulayacağını açıkladı.
LÜBNAN
Lübnan Sağlık Bakanı, 21 Aralık'ta Londra'dan gelen bir kişide corona virüsün yeni varyantının tespit edildiğini açıkladı.
AMERİKA BİRLEŞİK DEVLETLERİ
ABD, Colorado'da bir kişide 29 Aralık günü corona virüsün yeni varyantı tespit edildi. Devlet sağlık yetkilileri, 20'li yaşlarında olan adamın herhangi bir seyahat yapmadığını açıklarken Hastalık Kontrol ve Önleme Merkezleri (CDC), yeni mutasyonun büyük olasılıkla ülke genelinde dolaştığını söyledi.
İZLANDA
İzlanda Ulusal Yayın Servisi Salı günü, ülkeye seyahat eden 11 kişide corona virüsün yeni varyantı tespit edildiğini duyurdu.11 kişinin 10’unun İngiltere, birinin ise Danimarka’dan geldiği tespit edildi.
İSRAİL
İsrail, ülkede en az altı kişide corona virüsün yeni varyantı tespit edildiğini duyurdu.İsrailli araştırmacılar ise, düzinelerce şüpheli vaka olduğunu ve bu durumun mutasyonun ülkede hızla yayıldığını gösterdiğini açıkladı.
ÜRDÜN
Ürdün geçtiğimiz hafta iki kişide corona virüsün yeni varyantının tespit edildiğini açıkladı.
Sağlık Bakanı Nazir Obeidat, enfekte iki kişinin yakın zamanda İngiltere'den seyahat ettiğini ve her ikisinin de "çok sağlıklı” olduğunu söyledi.
ŞİLİ
Güney Amerika’da ilk mutasyon vakası Şili’de görüldü. Şili’de Sağlık Müsteşarı Paula Daza, Birleşik Krallık’tan seyahat eden bir kişide corona virüsün yeni varyantı tespit edildiğini açıkladı.
BREZİLYA
Şili’den iki gün sonra Brezilya’da iki kişide corona virüsün yeni varyantı tespit edildi.
NİJERYA - GÜNEY AFRİKA
Nijerya ve Güney Afrika corona virüsün yeni varyantının ülkelerinde tespit edildiğini açıkladı. İngiltere, 23 Aralık'ta Güney Afrika'dan kaynaklanan farklı, muhtemelen daha bulaşıcı bir corona virüs varyantı bulduğunu duyurdu. 24 Aralık'ta Nijerya, virüsün Birleşik Krallık ve Güney Afrika'da bulunanlardan başka bir varyantının olduğunu açıkladı.
İngiltere, Eylül ayında corona virüsün yeni varyantını bildiren ilk ülke oldu.
Aralık ayında Sağlık Bakanı Matt Hancock, yeni varyantın "kontrolden çıktığını" söyledi. Hancock, hükümeti daha sıkı karantina tedbirleri almaya ve birçok ülkeye seyahat kısıtlaması getirmeye çağırdı.
İrlanda Başbakanı Micheal Martin Çarşamba günü televizyonda yaptığı bir konuşmada, ülkede corona virüsün yeni varyantının tahmin edilebilecek en kötü seviyede yayıldığını açıklarken herhangi bir rakam vermekten kaçındı.
HOLLANDA - BELÇİKA
Hollanda, İngiltere'den sonra corona virüsün yeni varyantının bulduğunu açıklayan ilk Avrupa ülkelerinden biri oldu.
22 Aralık'ta Hollanda Sağlık Bakanı Hugo de Jonge, yeni varyantın Amsterdam bölgesinde iki vakada bulunduğunu söyledi.
Afp’ye göre, Belçika’da Aralık başında en az dört kişide corona virüsün yeni varyantı tespit edildi.
Belçika Sağlık Bakanlığı sözcüsü Yves Van Laethem, "Tespit edilen sayı çok değil ama daha fazla olması da imkansız değil" şeklinde konuştu.
TÜRKİYE
Türkiye Sağlık Bakanı Fahrettin Koca, geçtiğimiz gün 15 kişide corona virüsün yeni varyantının tespit edildiğini açıkladı. Koca, kişilerin karantina altına alındıklarını belirtti.
Koca, İngiltere'den son dönemde yurda giriş yapan 15 kişide yeni mutasyon ile uyumlu virüs tespit edilmesi üzerine, bu ülkeden yurda girişlerin geçici olarak tamamen durdurulduğunu duyurdu.
FRANSA
Fransa corona virüs mutasyonunun ilk vakasını Noel Günü'nde tespit etti. Yetkililer, kişinin Londra'dan dönen bir Fransız vatandaşı olduğunu söyledi.
İSVEÇ - DANİMARKA
İsveç sağlık kurumunun 26 Aralık'ta yaptığı açıklamada, İngiltere'den ülkeye gelen bir yolcuda corona virüsün yeni varyantı tespit edildi. Yetkililer enfekte olan kişinin izole edildiğini ve daha sonra herhangi bir vakanın tespit edilmediğini açıkladı.
Dünya Sağlık Örgütü, Noel haftasında Danimarka'da dokuz kişide corona virüsün yeni varyantının tespit edildiğini açıkladı.
İSPANYA - PORTEKİZ
İspanya’da sağlık yetkilileri 26 Aralık'ta ülkede corona virüsün yeni varyantının görüldüğü dört kişi olduğunu açıkladı.
Bu kişilerin İngiltere'den gelen kişiler olduğunu belirten yetkililerden Madrid bölge hükümetinin sağlık şef yardımcısı Antonio Zapatero, "Hastalar ciddi şekilde hasta değil. Bu türün daha bulaşıcı olduğunu biliyoruz, ancak daha ciddi hastalığa neden olmuyor" dedi.
Portekiz, 21 Aralık itibarıyla Portekiz'in özerk bölgesi Madeira adasında en az 18 corona virüs varyantının tespit edildiğini açıkladı.
İSVİÇRE
kayak pistlerini Noel ve yeni yıl tatilleri döneminde açık tutan tek Avrupa ülkesi olan İsviçre’de Federal Halk Sağlığı Dairesi (FOPH) 26 Aralık'ta yaptığı açıklamada, corona virüsün yeni varyantının üç kişide görüldüğünü açıkladı.
Hastalardan ikisinin Birleşik Krallık'ta yaşayan ancak ülkeyi sık sık ziyaret eden kişiler olduğu belirtilirken Federal Halk Sağlığı Dairesi sözcüsü "Tüm yakın temaslılar belirlendi ve karantinaya alındı" dedi.
ALMANYA
Alman sağlık yetkilileri 29 Aralık'ta, corona virüsün yeni varyantının Kasım ayından bu yana ülkede olduğunu söyledi. Yetkililer, varyantın sağlık sorunları olan ve hayatını kaybeden yaşlı bir hastada tespit edildiğini açıkladılar.
Ülke ayrıca, Londra’dan Frankfurt'a seyahat eden ve 20 Aralık'ta corona virüs testi pozitif çıkan bir kişide daha corona virüsün yeni varyantı tespit edildi.
İTALYA - MALTA
İtalyan yetkililer, İngiltere'den Roma'ya uçan bir çiftte corona virüsün yeni varyantını tespit ettiklerini söylediler.
Akdeniz’de ada ülkesi olan Malta, geçtiğimiz Çarşamba günü üç corona virüs mutasyonu vakası bildirdi.
KANADA
26 Aralık'ta Kanada'nın Ontario eyaletindeki bir çiftte, corona virüsün yeni varyantı tespit edildi.Yetkililer çiftin yüksek riskli temasta olmadıklarını ve kendi kendilerini karantinaya aldıklarını açıkladı.
JAPONYA
Japonya, Noel günü beş kişide corona virüsün yeni varyantının görüldüğünü açıkladı.
28 Aralık itibarıyla yeni seyahat kurallarını açıklayan ülkeye gidişlerden 72 saat önce negatif test ve vardıklarında iki hafta karantina kuralı getirildi.
TAYVAN - SİNGAPUR
Tayvan Sağlık Bakanı Chen Shih-chung Çarşamba günü yaptığı açıklamada, İngiltere'den seyahat eden 10 yaşındaki bir erkek çocuk da dahil olmak üzere üç yolcuda corona virüsün yeni varyantının tespit edildiğini açıkladı.
Singapur Sağlık Bakanlığı, 24 Aralık günü ülkelerinde corona virüsün yeni varyantının tespit edildiğini açıkladı.
AVUSTRALYA
Ülkede, New South Wales eyaletin baş sağlık görevlisi Kerry Chant, Birleşik Krallık'tan gelen bir uçuşun ardından Avustralya'nın New South Wales şehrinde corona virüsün yeni varyantını taşıyan iki vakasının tespit edildiğini söyledi.
BİRLEŞİK ARAP EMİRLİKLERİ
Birleşik Arap Emirlikleri'nden bir hükümet yetkilisi yaptığı açıklamada, ülkede corona virüsün yeni varyantının "sınırlı sayıda" bulunduğunu söyledi. Yetkili, vakaların yurt dışından geldiğini belirtirken hangi ülkeden ya da kaç kişide görüldüğü hakkında açıklama yapmadı.
HİNDİSTAN
Hindistan, 29 Aralık Salı günü sekiz kişide corona virüsün yeni varyantının tespit edildiğini açıkladı. Tespit edilen kişilerin hepsinin İngiltere’den geldiği belirtilirken kişilerin karantinaya alındıkları ifade edildi.
GÜNEY KORE
Kore Hastalık Kontrol ve Önleme Dairesi 28 Aralık'ta Güney Kore'de üç kişide corona virüsün yeni varyantının görüldüğünü duyurdu. 22 Aralık'ta Londra'dan gelen bir ailenin varyanta sahip olduğu ve o zamandan beri karantinada oldukları belirtildi.
ÇİN
Geçtiğimiz Çarşamba günü, Çin Hastalık Kontrol ve Önleme Merkezi ülkede corona virüsün yeni varyantının görüldüğünü duyurdu.
İngiltere'den Çin'e dönen 23 yaşındaki bir öğrencide tespit edilen mutasyonlu corona virüsün 14 Aralık'ta Şangay'da yapılan test sonrası ortaya çıktığı açıklandı.
FİNLANDİYA - NORVEÇ
Finlandiya Sağlık yetkilileri 28 Aralık Pazartesi günü yaptıkları açıklamada, İngiltere'den kısa süre önce dönen bir Finlandiya vatandaşında corona virüsün yeni varyantının görüldüğünü duyurdu. Norveç Halk Sağlığı Enstitüsü Pazar günü yaptığı açıklamada, Birleşik Krallık'tan gelen yolcuların ikisinde corona virüs mutasyonunun tespit edildiğini açıkladı.
PAKİSTAN
Pakistan, 29 Aralık'ta İngiltere'den gelen bir uçaktaki altı yolcuda corona virüsün yeni varyantının görüldüğünü duyurdu.Pakistan yönetimi, 4 Ocak’a kadar İngiltere’ye seyahat yasağı uygulayacağını açıkladı.
LÜBNAN
Lübnan Sağlık Bakanı, 21 Aralık'ta Londra'dan gelen bir kişide corona virüsün yeni varyantının tespit edildiğini açıkladı.
AMERİKA BİRLEŞİK DEVLETLERİ
ABD, Colorado'da bir kişide 29 Aralık günü corona virüsün yeni varyantı tespit edildi. Devlet sağlık yetkilileri, 20'li yaşlarında olan adamın herhangi bir seyahat yapmadığını açıklarken Hastalık Kontrol ve Önleme Merkezleri (CDC), yeni mutasyonun büyük olasılıkla ülke genelinde dolaştığını söyledi.
İZLANDA
İzlanda Ulusal Yayın Servisi Salı günü, ülkeye seyahat eden 11 kişide corona virüsün yeni varyantı tespit edildiğini duyurdu.11 kişinin 10’unun İngiltere, birinin ise Danimarka’dan geldiği tespit edildi.
İSRAİL
İsrail, ülkede en az altı kişide corona virüsün yeni varyantı tespit edildiğini duyurdu.İsrailli araştırmacılar ise, düzinelerce şüpheli vaka olduğunu ve bu durumun mutasyonun ülkede hızla yayıldığını gösterdiğini açıkladı.
ÜRDÜN
Ürdün geçtiğimiz hafta iki kişide corona virüsün yeni varyantının tespit edildiğini açıkladı.
Sağlık Bakanı Nazir Obeidat, enfekte iki kişinin yakın zamanda İngiltere'den seyahat ettiğini ve her ikisinin de "çok sağlıklı” olduğunu söyledi.
ŞİLİ
Güney Amerika’da ilk mutasyon vakası Şili’de görüldü. Şili’de Sağlık Müsteşarı Paula Daza, Birleşik Krallık’tan seyahat eden bir kişide corona virüsün yeni varyantı tespit edildiğini açıkladı.
BREZİLYA
Şili’den iki gün sonra Brezilya’da iki kişide corona virüsün yeni varyantı tespit edildi.
NİJERYA - GÜNEY AFRİKA
Nijerya ve Güney Afrika corona virüsün yeni varyantının ülkelerinde tespit edildiğini açıkladı. İngiltere, 23 Aralık'ta Güney Afrika'dan kaynaklanan farklı, muhtemelen daha bulaşıcı bir corona virüs varyantı bulduğunu duyurdu. 24 Aralık'ta Nijerya, virüsün Birleşik Krallık ve Güney Afrika'da bulunanlardan başka bir varyantının olduğunu açıkladı.
Kaynak:
Reklam alanı
Son dakika gelişmelerden anında haberdar olmak için WhatsApp haber kanalımıza katılın.
Gelişmelerden zamanında haberdar olmak istiyor musunuz? Google News’te KONHABER'e abone olun.
Yasal Uyarı: Yayınlanan haberler, köşe yazıları, fotoğraflar, yazı dizileri ve her türlü eserin tüm hakları
Mirajans Medya İletişim Reklam Haber ve Prodüksiyon A.Ş.'ye aittir. Kaynak gösterilerek bile olsa eserin bütünü veya
bir kısmı özel izin alınmadan kullanılamaz.
⚡ BU HABERE EMOJİYLE TEPKİ VER!
👏
1
❤️
0
😊
1
😡
8
👎
2
😂
1
😢
3
😲
2
Toplam 18 tepki














